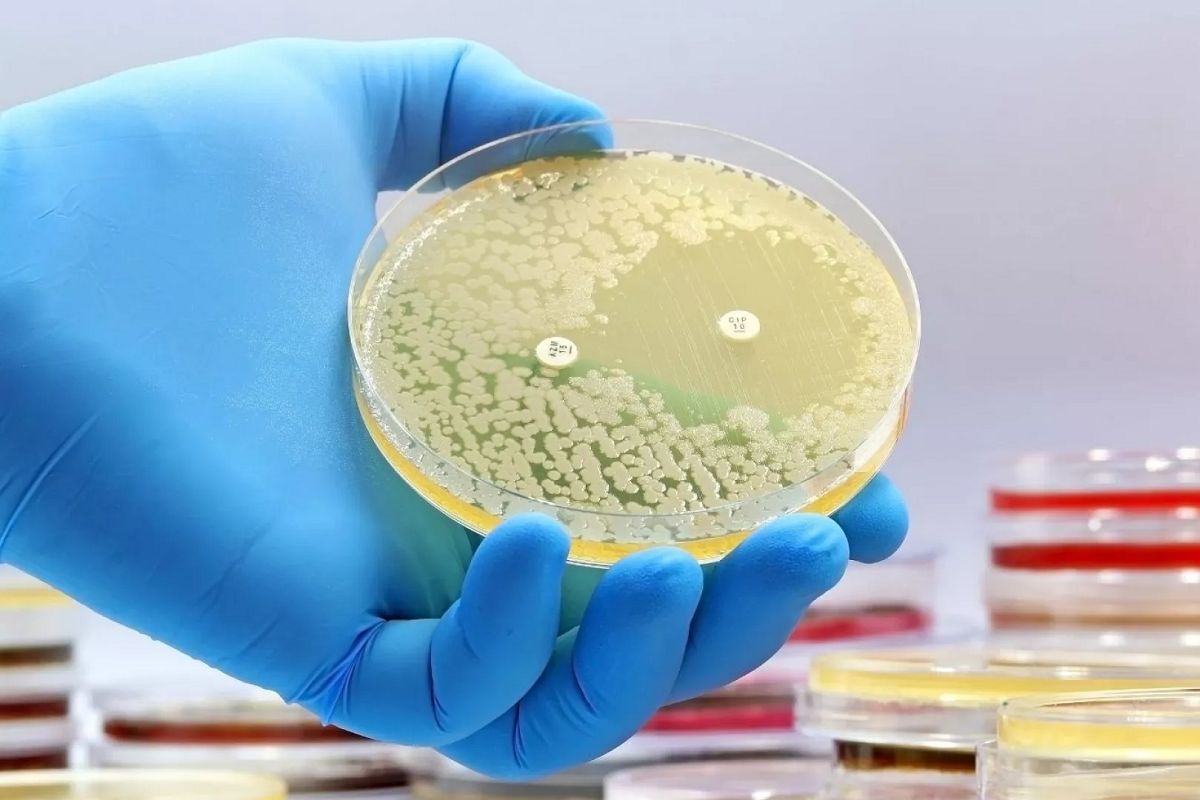

Most commonly used antibiotics. Top Prescribed Antibiotics of 2022: Analysis and Trends in Antibiotic Usage
How did antibiotic prescription patterns change in 2022. Which antibiotics were most commonly prescribed in the United States. What factors influence antibiotic prescribing rates across different regions and demographics. How can we address concerns about antibiotic resistance and overprescription.
Antibiotic Prescription Trends: A Comprehensive Overview
In 2015, healthcare providers in the United States prescribed a staggering 269.4 million antibiotic prescriptions, equivalent to 838 prescriptions per 1,000 persons. This data, extracted from the QuintilesIMS Xponent database, captures an estimated 88% of outpatient prescriptions nationwide. While this information provides a baseline for understanding antibiotic usage, it’s crucial to examine how these trends have evolved in recent years, particularly in 2022.
Are antibiotic prescription rates increasing or decreasing? The 2015 data serves as a reference point, but it’s essential to consider factors that may have influenced prescription patterns in subsequent years, such as changes in guidelines, increased awareness of antibiotic resistance, and the impact of the COVID-19 pandemic on healthcare practices.
![]()
Regional Disparities in Antibiotic Prescribing
The 2015 data revealed significant regional differences in antibiotic prescribing rates across the United States. The South led with 920 prescriptions per 1,000 persons, followed closely by the Midwest at 898. The Northeast recorded 867 prescriptions per 1,000 persons, while the West had notably lower rates at 632 per 1,000.
Have these regional disparities persisted or changed in recent years? Factors such as local healthcare policies, cultural attitudes towards antibiotics, and differences in disease prevalence may contribute to these variations. It’s worth investigating whether initiatives to promote responsible antibiotic use have had a more significant impact in certain regions.
State-by-State Analysis
A closer look at state-level data from 2015 reveals even more pronounced differences:
- Kentucky had the highest prescription rate at 1,256 per 1,000 persons
- West Virginia and Mississippi followed closely with rates exceeding 1,200
- Alaska had the lowest rate at 511 prescriptions per 1,000 persons
- Oregon and California also had relatively low rates, below 600 per 1,000
How have these state-level disparities evolved since 2015? Examining more recent data could reveal which states have made progress in reducing antibiotic prescriptions and which may require targeted interventions.

Demographic Factors Influencing Antibiotic Prescriptions
The 2015 data highlighted significant differences in antibiotic prescribing rates based on age and sex:
- Adults (≥20 years) received 850 prescriptions per 1,000 persons
- Children and adolescents (<20 years) received 778 prescriptions per 1,000 persons
- Females received 1,005 prescriptions per 1,000 persons
- Males received 663 prescriptions per 1,000 persons
Do these demographic trends persist in more recent data? Understanding the reasons behind these differences is crucial for developing targeted interventions and education programs. For instance, the higher prescription rate for females may be partially attributed to urinary tract infections, which are more common in women.
Most Prescribed Antibiotic Classes and Agents
In 2015, the top five antibiotic classes prescribed were:
- Penicillins (192 prescriptions per 1,000 persons)
- Macrolides (154 prescriptions per 1,000 persons)
- Cephalosporins (113 prescriptions per 1,000 persons)
- Fluoroquinolones (101 prescriptions per 1,000 persons)
- Beta-lactams with increased activity (79 prescriptions per 1,000 persons)
The most frequently prescribed individual antibiotics were:

- Amoxicillin (171 prescriptions per 1,000 persons)
- Azithromycin (144 prescriptions per 1,000 persons)
- Amoxicillin/clavulanic acid (79 prescriptions per 1,000 persons)
- Cephalexin (67 prescriptions per 1,000 persons)
- Ciprofloxacin (63 prescriptions per 1,000 persons)
Have there been shifts in the popularity of specific antibiotic classes or agents since 2015? Factors such as emerging resistance patterns, new clinical guidelines, and the introduction of novel antibiotics may have influenced prescribing practices.
Antibiotic Prescribing by Healthcare Provider Specialty
The 2015 data revealed significant variations in antibiotic prescribing rates across different healthcare provider specialties:
- Primary Care Physicians: 466 prescriptions per provider
- Emergency Medicine: 457 prescriptions per provider
- Physician Assistants and Nurse Practitioners: 363 prescriptions per provider
- Dermatology: 628 prescriptions per provider
- Dentistry: 205 prescriptions per provider
How have these patterns evolved in recent years? The high prescribing rate among dermatologists is particularly noteworthy and warrants further investigation. Have educational initiatives or changes in practice guidelines impacted prescribing behaviors across different specialties?
Addressing Antibiotic Resistance and Overprescription
The high rates of antibiotic prescriptions observed in the 2015 data raise concerns about antibiotic resistance and overprescription. Have these issues been effectively addressed in subsequent years? Several strategies have been proposed and implemented to promote responsible antibiotic use:
- Antibiotic stewardship programs in healthcare facilities
- Enhanced education for both healthcare providers and the public
- Implementation of rapid diagnostic tests to distinguish between viral and bacterial infections
- Development of clinical decision support tools
- Increased monitoring and reporting of antibiotic prescribing patterns
To what extent have these initiatives been successful in reducing unnecessary antibiotic prescriptions? Examining more recent data could reveal the impact of these interventions and highlight areas where further efforts are needed.
The Impact of COVID-19 on Antibiotic Prescribing
The COVID-19 pandemic has undoubtedly influenced healthcare practices, including antibiotic prescribing patterns. Several factors may have affected antibiotic use during this period:
![]()
- Reduced in-person healthcare visits potentially leading to fewer antibiotic prescriptions
- Increased use of telemedicine, which may have changed prescribing behaviors
- Concerns about secondary bacterial infections in COVID-19 patients
- Changes in the prevalence of common bacterial infections due to social distancing measures
How have these factors influenced antibiotic prescription rates in 2022 compared to pre-pandemic levels? Analyzing this data could provide valuable insights into the pandemic’s long-term impact on antibiotic use.
Telemedicine and Antibiotic Prescribing
The rapid adoption of telemedicine during the COVID-19 pandemic may have had significant effects on antibiotic prescribing practices. Has the increased use of virtual consultations led to changes in how antibiotics are prescribed? Some potential impacts include:
- Reduced ability to perform physical examinations, potentially affecting diagnostic accuracy
- Increased reliance on patient-reported symptoms
- Changes in patient expectations and provider behaviors in virtual settings
Investigating the relationship between telemedicine adoption and antibiotic prescribing patterns could provide valuable insights for future healthcare delivery models.

Emerging Trends in Antibiotic Development and Use
While the 2015 data provides a snapshot of antibiotic use, it’s crucial to consider how the landscape of antibiotic development and use has evolved since then. Several key trends and developments may have influenced antibiotic prescribing patterns in recent years:
- Introduction of new antibiotics targeting resistant bacteria
- Increased focus on narrow-spectrum antibiotics to reduce collateral damage to the microbiome
- Growing interest in alternative approaches, such as bacteriophage therapy and immunomodulators
- Advancements in rapid diagnostic technologies for identifying bacterial infections and antibiotic susceptibility
How have these developments impacted antibiotic prescribing practices in 2022? Examining the adoption rates of newer antibiotics and alternative therapies could provide insights into the evolving approach to treating bacterial infections.
The Role of Rapid Diagnostics
Advancements in rapid diagnostic technologies have the potential to significantly impact antibiotic prescribing patterns. These tools can help healthcare providers quickly distinguish between viral and bacterial infections, as well as identify specific pathogens and their antibiotic susceptibilities. Some key questions to consider:

- To what extent have rapid diagnostic tests been adopted in clinical practice since 2015?
- How has the use of these tests influenced antibiotic prescribing rates and the selection of specific antibiotics?
- Are there notable differences in the adoption and impact of rapid diagnostics across different healthcare settings or regions?
Analyzing the correlation between the implementation of rapid diagnostic technologies and changes in antibiotic prescribing patterns could provide valuable insights into their effectiveness in promoting responsible antibiotic use.
International Comparisons and Global Antibiotic Stewardship Efforts
While the focus of the original data is on the United States, it’s important to consider antibiotic prescribing patterns in a global context. How do antibiotic prescription rates in the U.S. compare to those in other countries, particularly in 2022? Several factors may influence these international differences:
- Variations in healthcare systems and access to medical care
- Differences in regulatory frameworks governing antibiotic use
- Cultural attitudes towards antibiotics and healthcare
- The prevalence of antibiotic-resistant infections in different regions
Examining global antibiotic stewardship initiatives and their outcomes could provide valuable insights for improving practices in the United States. Have any countries implemented particularly successful strategies for reducing antibiotic overuse that could be adapted for use in the U.S.?

The One Health Approach
The One Health approach, which recognizes the interconnectedness of human, animal, and environmental health, has gained traction in recent years as a framework for addressing antibiotic resistance. How has this approach influenced antibiotic prescribing practices and policies since 2015? Key considerations include:
- Efforts to reduce antibiotic use in agriculture and animal husbandry
- Increased surveillance of antibiotic-resistant organisms in the environment
- Collaborative initiatives between human and veterinary medicine to promote responsible antibiotic use
Investigating the impact of One Health initiatives on antibiotic prescribing patterns in both human and veterinary medicine could provide a more comprehensive understanding of progress in combating antibiotic resistance.
The Future of Antibiotic Prescribing: Challenges and Opportunities
As we analyze the most prescribed antibiotics of 2022 and compare them to the 2015 data, it’s crucial to consider the future trajectory of antibiotic use. Several challenges and opportunities are likely to shape antibiotic prescribing practices in the coming years:

- The ongoing threat of antibiotic resistance and the need for continued stewardship efforts
- The potential impact of artificial intelligence and machine learning in guiding antibiotic prescribing decisions
- The development of novel approaches to treating bacterial infections, such as antibiotic-enhancing compounds or immune-based therapies
- The role of personalized medicine in tailoring antibiotic treatments based on individual patient factors and pathogen characteristics
How are healthcare providers, researchers, and policymakers preparing to address these challenges and capitalize on emerging opportunities? Examining current initiatives and research priorities could provide insights into the future landscape of antibiotic prescribing.
The Role of Patient Education and Engagement
Patient expectations and behaviors play a significant role in antibiotic prescribing patterns. Have efforts to educate the public about appropriate antibiotic use intensified since 2015? Key questions to consider include:

- How effective have public awareness campaigns been in reducing patient demand for unnecessary antibiotics?
- Have there been changes in how healthcare providers communicate with patients about antibiotic use?
- What role can digital health tools and patient portals play in promoting responsible antibiotic use?
Analyzing the impact of patient education initiatives on antibiotic prescribing rates could provide valuable insights for future public health strategies.
Outpatient Antibiotic Prescriptions — United States, 2015 | Antibiotic Use
Healthcare providers prescribed 269.4 million antibiotic prescriptions—equivalent to 838 antibiotic prescriptions per 1000 persons.
Print only version: Outpatient Antibiotic Prescriptions — United States, 2015 pdf icon[PDF – 366 KB]
Citation: Centers for Disease Control and Prevention. Outpatient antibiotic prescriptions — United States, 2015.
Systemic oral antibiotics were extracted from the QuintilesIMS Xponent database. QuintilesIMS captured an estimated 88% of outpatient prescriptions for any medication nationally, reconciled them to wholesale deliveries, and projected to 100% coverage. These data represent all outpatient antibiotic prescriptions from community pharmacies from all payers, but exclude federal facilities. Provider specialties are taken from the American Medical Association (AMA) self-designated practice specialties and categorized into one of 17 groups.
Population data were obtained from the U.S. Census bridging files.
References
Hicks, L.A., et al., US Outpatient Antibiotic Prescribing Variation According to Geography, Patient Population, and Provider Specialty in 2011. Clin Infect Dis, 2015. 60(9): p. 1308-16.
| Age group | NUMBER OF ANTIBIOTIC PRESCRIPTIONS (MILLIONS) | ANTIBIOTIC PRESCRIPTIONS PER 1,000 PERSONS, RATE |
|---|---|---|
| <20 yearsa | 64.7 | 778 |
| ≥20 yearsa | 203.3 | 850 |
| Sex | NUMBER OF ANTIBIOTIC PRESCRIPTIONS (MILLIONS) | ANTIBIOTIC PRESCRIPTIONS PER 1,000 PERSONS, RATE |
|---|---|---|
| Femalea | 164. 0 | 1,005 |
| Malea | 104.9 | 663 |
| Region | NUMBER OF ANTIBIOTIC PRESCRIPTIONS (MILLIONS) | ANTIBIOTIC PRESCRIPTIONS PER 1,000 PERSONS, RATE |
|---|---|---|
| Northeastb | 48.8 | 867 |
| Midwestb | 61.0 | 898 |
| Southb | 111.5 | 920 |
| Westb | 48.1 | 632 |
aTotals may not add to all oral prescriptions (269.4 million) due to missing data
bTotals may not add to all oral prescriptions (269.4 million) due to rounding.
Table 2. Top oral antibiotic classes and agents prescribed—United States, 2015
| ANTIBIOTIC CLASS | NUMBER OF ANTIBIOTIC PRESCRIPTIONS (MILLIONS) | ANTIBIOTIC PRESCRIPTIONS PER 1,000 PERSONS, RATE |
|---|---|---|
| Penicillins | 61.6 | 192 |
| Macrolides | 49.4 | 154 |
| Cephalosporins | 36.3 | 113 |
| Fluoroquinolones | 32.5 | 101 |
| Beta-lactams, increased activity | 25.3 | 79 |
| ANTIBIOTIC AGENT | NUMBER OF ANTIBIOTIC PRESCRIPTIONS (MILLIONS) | ANTIBIOTIC PRESCRIPTIONS PER 1,000 PERSONS, RATE |
|---|---|---|
| Amoxicillin | 54.8 | 171 |
| Azithromycin | 46.2 | 144 |
| Amoxicillin/clavulanic acid | 25. 3 | 79 |
| Cephalexin | 21.4 | 67 |
| Ciprofloxacin | 20.3 | 63 |
Table 3. Oral antibiotic prescribing by provider specialty — United States, 2015
| PROVIDER SPECIALTY | NUMBER OF ANTIBIOTIC PRESCRIPTIONS (MILLIONS) | ANTIBIOTIC PRESCRIPTIONS PER PROVIDER, RATE |
|---|---|---|
| Primary Care Physicians | 110.8 | 466 |
| Physician Assistants and Nurse Practitioners | 62.9 | 363 |
| Surgical Specialties | 19.5 | 219 |
| Dentistry | 25.1 | 205 |
| Emergency Medicine | 14.8 | 457 |
| Dermatology | 7. 1 | 628 |
| Obstetrics/Gynecology | 6.3 | 167 |
| Other | 22.9 | 110 |
| All Providers | 269.4 | 295 |
Figure 1. Antibiotic prescriptions per 1000 persons by state (sextiles) for all ages — United States, 2015.
This project was made possible through a partnership with the CDC Foundation. Support for this project was provided by The Pew Charitable Trusts.
| State | Number of prescriptions per 1000 persons, Rate |
|---|---|
| Alabama | 1,149 |
| Alaska | 511 |
| Arizona | 769 |
| Arkansas | 1,154 |
| California | 590 |
| Colorado | 624 |
| Connecticut | 843 |
| Delaware | 915 |
| District Of Columbia | 979 |
| Florida | 706 |
| Georgia | 830 |
| Hawaii | 640 |
| Idaho | 720 |
| Illinois | 845 |
| Indiana | 964 |
| Iowa | 1,018 |
| Kansas | 1,016 |
| Kentucky | 1,256 |
| Louisiana | 1,174 |
| Maine | 732 |
| Maryland | 794 |
| Massachusetts | 759 |
| Michigan | 918 |
| Minnesota | 696 |
| Mississippi | 1,254 |
| Missouri | 944 |
| Montana | 662 |
| Nebraska | 1,072 |
| Nevada | 733 |
| New Hampshire | 728 |
| New Jersey | 903 |
| New Mexico | 724 |
| New York | 898 |
| North Carolina | 872 |
| North Dakota | 864 |
| Ohio | 964 |
| Oklahoma | 966 |
| Oregon | 582 |
| Pennsylvania | 895 |
| Rhode Island | 888 |
| South Carolina | 936 |
| South Dakota | 893 |
| Tennessee | 1,165 |
| Texas | 895 |
| Utah | 779 |
| Vermont | 668 |
| Virginia | 804 |
| Washington | 610 |
| West Virginia | 1,319 |
| Wisconsin | 745 |
| Wyoming | 789 |
Top of Page
Amoxicillin – StatPearls – NCBI Bookshelf
Continuing Education Activity
Amoxicillin is one of the most commonly used antibiotics in the primary care setting.
It is an amino-penicillin, created by adding an extra amino group to penicillin to battle antibiotic resistance. Amoxicillin covers a wide variety of gram-positive bacteria, with some added gram-negative coverage compared to penicillin. Like penicillin, it covers most Streptococcus species and has improved coverage of Listeria monocytogenes and Enterococcus spp. It also has coverage over Haemophilus influenzae, some Escherichia coli, Actinomyces spp., Clostridium species, Salmonella spp., Shigella spp., and Corynebacteria species. This activity covers amoxicillin, a beta-lactam antimicrobial that interprofessional team members need to review its indications, coverage, contraindications, and adverse event profile to manage patients with infectious disease optimally.
Objectives:
Outline the indications for initiating amoxicillin as an anti-infective strategy for patient care.
Identify the mechanism of action of amoxicillin and its target coverage.

Summarize the adverse effects of amoxicillin.
Explain the importance of antimicrobial stewardship and how it affects antimicrobial selection to improve care coordination among the interprofessional team when initiating amoxicillin antimicrobial therapy.
Access free multiple choice questions on this topic.
Indications
Amoxicillin is one of the most commonly used antibiotics in the primary care setting. It is an amino-penicillin, created by adding an extra amino group to penicillin to battle antimicrobial resistance. Amoxicillin covers a wide variety of gram-positive bacteria, with some added gram-negative coverage compared to penicillin. Like penicillin, it covers most Streptococcus species and is also effective against Listeria monocytogenes and Enterococcus species. It also covers Haemophilus influenza, some Escherichia coli, Actinomyces species, Clostridium species, Salmonella species, Shigella species, and Corynebacteria species.
FDA-approved Indications
Amoxicillin is indicated in treating infections due to susceptible (only beta-lactamase–negative) isolates of the selected bacteria in the conditions listed below.
Ear, nose, and throat infections: Treatment of tonsillitis, pharyngitis, and otitis media in adults and pediatric patients ≥12 years of age. The microbiological spectrum is infections due to beta-lactamase-negative Streptococcus species (alpha- and beta-hemolytic isolates only), Streptococcus pneumoniae, Staphylococcus species, or Haemophilus influenza.[1]
Helicobacter pylori eradication: Triple therapy for Helicobacter pylori with clarithromycin, amoxicillin, and lansoprazole to eradicate Helicobacter pylori reduces the risk of duodenal ulcer recurrence. Dual treatment with amoxicillin and lansoprazole is also FDA approved to eradicate Helicobacter pylori infection.[2]
Lower respiratory tract infections: Treatment of lower respiratory tract infection due to beta-lactamase-negative Streptococcus species (alpha- and beta-hemolytic strains only), pneumococcus, Staphylococcus species, or Haemophilus influenzae.
For community-acquired pneumonia, IDSA recommends a combination of amoxicillin and macrolide.[3]
Acute Bacterial Sinusitis: Treating infections due to beta-lactamase-negative Streptococcus species (alpha- and beta-hemolytic isolates only), Streptococcus pneumoniae, Staphylococcus species, or Haemophilus influenzae.[4]
Skin and skin structure infections: Immediate release: Treatment of skin and skin structure infections due to beta-lactamase-negative Streptococcus species (alpha and beta-hemolytic strains only), Staphylococcus species, or Escherichia coli.[5]
Urinary tract infection: Treatment of the genitourinary tract infections. Organisms include beta-lactamase-negative Escherichia coli, Proteus mirabilis, or Enterococcus faecalis.[6]
The Centers for Disease Control and Prevention (CDC) recommends using amoxicillin for post-exposure prophylaxis for anthrax(second-line agent).
[7]
Off-label Clinical Uses
Infectious endocarditis prophylaxis(cardiac conditions associated with the high risk such as the presence of prosthetic cardiac valve or congenital heart disease)[9]
Actinomycosis[11]
Mechanism of Action
Amoxicillin is in the class of beta-lactam antimicrobials. Beta-lactams act by binding to penicillin-binding proteins that inhibit a process called transpeptidation (the cross-linking process in cell wall synthesis), leading to activation of autolytic enzymes in the bacterial cell wall. This process leads to lysis of the cell wall, thus destroying the bacterial cell. This type of activity is referred to as bactericidal killing.[12]
Amoxicillin administration can also be in combination with a beta-lactamase inhibitor. Some examples of these are clavulanic acid and sulbactam. These beta-lactamase inhibitors work by binding irreversibly to the catalytic site of an organism’s beta-lactamase enzyme, which causes resistance to the original beta-lactam ring of amoxicillin.
These drugs do not have inherent bactericidal activity; however, they may broaden amoxicillin’s spectrum to organisms that produce the beta-lactamase enzyme when combined with amoxicillin.[13]
Administration
Bactericidal antimicrobials, such as amoxicillin, often are most effective in a “time-dependent” manner rather than a “concentration-dependent” manner. Time-dependent refers to the time that serum concentrations exceed the minimum-inhibitor-concentration (MIC) for the microorganism. Therefore, they are often dosed more frequently, rather than the concentration-dependent drugs, which can be dosed, for example, daily. The more “around-the-clock” dosing provides minor variation in peak and trough serum concentrations.[14]
Amoxicillin is an oral antimicrobial; whereas, ampicillin (which is structurally similar) can be given orally, intravenously, or intramuscularly. Amoxicillin comes in immediate-release or extended-release tablets. It also comes in a chewable tablet or a suspension.
It may be mixed (after thoroughly shaking) and administered with formula, milk, water, fruit juice, ginger ale, or other cold drinks if given in suspension. The administration should take place immediately after mixing. Patients should not crush Extended-release tablets, and the administration should be within 1 hour after finishing a meal. Amoxicillin is sometimes preferred over penicillin in children because of its taste.
Dosing
In adults, 750-1750 mg/day in divided doses every 8-12 hours.
In Pediatric Patients > 3 Months of Age, 20-45 mg/kg/day in divided doses every 8-12 hours.
Dosing for H. pylori Infection: Triple therapy: 1 gram amoxicillin, 500 mg clarithromycin, and 30 mg lansoprazole, all given twice daily (every 12 hours) for 14 days.
Dual therapy: 1 gram amoxicillin and 30 mg lansoprazole, each given three times daily.
Dosing in Renal Impairment
Patients with impaired renal function do not generally require a reduction in dose unless the impairment is severe.

Severely impaired patients with a glomerular filtration rate of < 30 mL/min should not receive an 875-mg dose.
Patients with a glomerular filtration rate of 10 to 30 mL/min should receive 500 mg or 250 mg every 12 hours, depending on the severity of the infection.
Patients with a glomerular filtration rate less than 10 mL/min should receive 500 mg or 250 mg every 24 hours, depending on the severity of the infection.
Hemodialysis patients should receive 500 mg or 250 mg every 24 hours, depending on the severity of the infection. They should receive an additional dose both during and at the end of dialysis.
Geriatric Consideration
It is important to note that it is excreted in most people by the kidney, and some renal adjustment and extra caution may be necessary for renal insufficiency. Because elderly patients are more likely to have decreased renal function, the clinician should adjust the dose.
It is reported to be partially dialyzable, and therefore, immediate-release tablets can be an option for dosing after hemodialysis.[15]
Pregnancy
Amoxicillin is a pregnancy category B drug under the old FDA classification system, which means there have been no studies demonstrating clear risk. Amoxicillin is widely used in pregnant women. Based on available data, amoxicillin is usually considered compatible for use during pregnancy. The dose and duration of amoxicillin therapy in pregnant and postpartum women are the same as in nonpregnant adults.[16]
Breastfeeding
An exclusively breastfed infant would be expected to receive a maximum daily dosage of about 0.1 mg/kg of amoxicillin with a maternal dose of 500 mg three times daily. This amounts to 0.25 to 0.5% of a typical infant amoxicillin dosage. As discussed above, amoxicillin produces low levels in milk that are not expected to cause adverse effects in breastfed infants.
Occasionally, rash and disruption of the infant’s gastrointestinal flora, resulting in diarrhea or thrush, have been reported. Consequently, amoxicillin is acceptable in nursing mothers.[17]
Adverse Effects
Common Adverse Drug Reactions: Amoxicillin is well-tolerated, but some common complaints can be gastrointestinal (GI) symptoms, such as nausea, vomiting, and diarrhea.
Superinfections: Mucocutaneous candidiasis, clostridium difficile associated diarrhea. Of note, patients who take amoxicillin may have less diarrhea than those who take ampicillin because of better absorption in the gut.[18]
Nephrotoxicity: Crystalluria, interstitial nephritis[19][20]
Hypersensitivity
Reactions: Amoxicillin can lead to type-I, II, III, or IV reactions. It is essential to differentiate between a type-I and type-IV hypersensitivity reaction because one may be more dangerous than the other. A type-I hypersensitivity reaction is an IgE-mediated response to a sensitized patient that triggers widespread histamine release leading to an urticarial-like pruritic rash or severe anaphylaxis.
A type-IV hypersensitivity reaction is not mediated by histamine release and is more papular or morbilliform and often not itchy. Professionals suggest that almost all patients that receive amoxicillin inadvertently for infectious mononucleosis develop a maculopapular rash caused by a type IV-mediated hypersensitivity reaction. These types of reactions are not known to cause anaphylaxis.[21]
Hepatotoxicity: instances of idiosyncratic liver injury have been reported in persons receiving amoxicillin. The serum enzyme pattern associated with the liver injury is the hepatocellular pattern with marked elevations in AST and ALT. There are minimal elevations in alkaline phosphatase. Most patients recover rapidly after withdrawal of amoxicillin and rapid recovery after withdrawal. The cause of the liver injury associated with amoxicillin use is hypersensitivity. Rare cases of acute liver failure and vanishing bile duct syndrome have been reported. Corticosteroids have often been used to treat the allergic manifestations of penicillin-related immunoallergic hepatitis.
Likelihood score: B (highly likely but rare cause of clinically apparent liver injury).[22]
Postmarketing Adverse Drug Reactions
Gastrointestinal: black hairy tongue, pseudomembranous colitis, hemorrhagic colitis[23]
Neurological: reversible hyperactivity, agitation, anxiety, insomnia, confusion, convulsions, aseptic meningitis[24]
Hematological: hemolytic anemia, thrombocytopenia, thrombocytopenic purpura, eosinophilia, leukopenia, and neutropenia[25]
Dermatological: serum sickness-like reactions, erythematous maculopapular rashes, exfoliative dermatitis, toxic epidermal necrolysis, hypersensitivity vasculitis[26]
Contraindications
Any previous anaphylactic or serious skin reaction (for example, Stevens-Johnson syndrome) to amoxicillin or any other beta-lactam is a contraindication to amoxicillin. These reactions may have crossover sensitivity with cephalosporins or carbapenems. However, it is important to note that newer data has suggested a much lower cross-reactivity with cephalosporins and carbapenems than once suspected.

An important consideration is determining if the patient’s allergic rash is a type-I or a type-IV hypersensitivity reaction. Occasionally patients will report a childhood allergy to amoxicillin, which is, in fact, a type-IV-mediated hypersensitivity reaction, often in the setting of infectious mononucleosis; this is not a contraindication to giving repeat amoxicillin. However, a type-1 mediated hypersensitivity reaction is a contraindication given that a repeat exposure puts the patient at risk for anaphylaxis.
Skin testing has been approved to help assist in hypersensitivity to penicillins. Reports are that the risk of an allergic reaction in a patient with a positive skin test is roughly four percent. In contrast, a negative skin test has a relatively high sensitivity in ruling out a type-I hypersensitivity reaction.[27]
Monitoring
It is essential to be aware of hypersensitivity reactions, and the patient should understand to notify their physician of any rashes.
[27]
In a patient on a short-term course of amoxicillin, no specific laboratory monitoring parameters are suggested. However, during prolonged administration, such as for osteomyelitis, it is essential to monitor renal and hepatic function and hematologic function periodically throughout treatment.[22]
Mild diarrhea is often tolerable. However, prolonged diarrhea with fever and abdominal pain should prompt evaluation by a clinician for CDAD.[28]
Penicillins in high doses can cause seizures which is a concern, especially in patients with renal failure.[29]
Toxicity
A prospective study of 51 pediatric patients at a poison-control center proposed that less than 250 mg/kg of amoxicillin overdosages are not associated with significant clinical symptoms(Product labeling FDA).
Clinical Features
Interstitial nephritis resulting in oliguric renal failure has been reported in a small number of patients after overdosage with amoxicillin.
[19][20]
Crystalluria leading to renal failure has been reported after amoxicillin overdosage in adult and pediatric patients.[30]
Management
In case of overdose, discontinue medication, treat symptomatically.
Maintain airway, breathing, and circulation.
For updated information about the overdose of amoxicillin, call a poison control center (1-800-222-1222)
Enhancing Healthcare Team Outcomes
Amoxicillin is a common antimicrobial often prescribed by nurse practitioners, primary care providers, and internists. The drug is safe, but it is essential always to get a good history of allergy before prescribing the medication. Due to the widespread use of amoxicillin, all healthcare providers should understand the mechanism, resistance patterns, adverse drug reactions, and toxicity management.[27][32]
The clinician usually initiates amoxicillin therapy for appropriate indication.
However, a pharmacist should verify the dosing and duration are correct for the infection being treated and confirm that no drug interactions could impede treatment. Nursing staff can counsel on administration, verify adherence. Additionally, nurses should educate the patient not to discontinue amoxicillin when they start to feel better. If the nurse or pharmacist encounters any issues, they should address them with the prescriber immediately.
In case of significant overdose, triage nurses should admit the patient. Emergency physicians need to evaluate and manage nephrotoxicity. Nephrologist consultation is necessary for hemodialysis. Consult a medical toxicologist or poison control center for the latest information.[33] Infectious disease specialists should ensure proper management of pseudomembranous colitis resulting from irrational amoxicillin use. Additionally, infectious disease specialists should emphasize the importance of antimicrobial stewardship. Antimicrobial stewardship is a coordinated program that encourages the proper use of antimicrobials, enhances patient outcomes, decreases microbial resistance, and reduces the spread of infections caused by multidrug-resistant organisms.
[34]
As depicted above, clinicians(MDs, DOs, NPs, PAs), specialists, pharmacists, nurses, and other healthcare providers should collaborate to maximize efficacy and minimize adverse drug reactions related to amoxicillin therapy. This type of interprofessional team approach and antimicrobial stewardship will improve the likelihood of more favorable patient outcomes.[35] [Level 2]
Review Questions
Access free multiple choice questions on this topic.
Comment on this article.
References
- 1.
Shulman ST, Bisno AL, Clegg HW, Gerber MA, Kaplan EL, Lee G, Martin JM, Van Beneden C., Infectious Diseases Society of America. Clinical practice guideline for the diagnosis and management of group A streptococcal pharyngitis: 2012 update by the Infectious Diseases Society of America. Clin Infect Dis. 2012 Nov 15;55(10):e86-102. [PMC free article: PMC7108032] [PubMed: 22965026]
- 2.
Matsumoto H, Shiotani A, Graham DY.
Current and Future Treatment of Helicobacter pylori Infections. Adv Exp Med Biol. 2019;1149:211-225. [PMC free article: PMC6918954] [PubMed: 31016626]- 3.
Chow AW, Benninger MS, Brook I, Brozek JL, Goldstein EJ, Hicks LA, Pankey GA, Seleznick M, Volturo G, Wald ER, File TM., Infectious Diseases Society of America. IDSA clinical practice guideline for acute bacterial rhinosinusitis in children and adults. Clin Infect Dis. 2012 Apr;54(8):e72-e112. [PubMed: 22438350]
- 4.
Rosenfeld RM, Piccirillo JF, Chandrasekhar SS, Brook I, Ashok Kumar K, Kramper M, Orlandi RR, Palmer JN, Patel ZM, Peters A, Walsh SA, Corrigan MD. Clinical practice guideline (update): adult sinusitis. Otolaryngol Head Neck Surg. 2015 Apr;152(2 Suppl):S1-S39. [PubMed: 25832968]
- 5.
Sartelli M, Guirao X, Hardcastle TC, Kluger Y, Boermeester MA, Raşa K, Ansaloni L, Coccolini F, Montravers P, Abu-Zidan FM, Bartoletti M, Bassetti M, Ben-Ishay O, Biffl WL, Chiara O, Chiarugi M, Coimbra R, De Rosa FG, De Simone B, Di Saverio S, Giannella M, Gkiokas G, Khokha V, Labricciosa FM, Leppäniemi A, Litvin A, Moore EE, Negoi I, Pagani L, Peghin M, Picetti E, Pintar T, Pupelis G, Rubio-Perez I, Sakakushev B, Segovia-Lohse H, Sganga G, Shelat V, Sugrue M, Tarasconi A, Tranà C, Ulrych J, Viale P, Catena F.
2018 WSES/SIS-E consensus conference: recommendations for the management of skin and soft-tissue infections. World J Emerg Surg. 2018;13:58. [PMC free article: PMC6295010] [PubMed: 30564282]- 6.
Tan CW, Chlebicki MP. Urinary tract infections in adults. Singapore Med J. 2016 Sep;57(9):485-90. [PMC free article: PMC5027397] [PubMed: 27662890]
- 7.
Hendricks KA, Wright ME, Shadomy SV, Bradley JS, Morrow MG, Pavia AT, Rubinstein E, Holty JE, Messonnier NE, Smith TL, Pesik N, Treadwell TA, Bower WA., Workgroup on Anthrax Clinical Guidelines. Centers for disease control and prevention expert panel meetings on prevention and treatment of anthrax in adults. Emerg Infect Dis. 2014 Feb;20(2) [PMC free article: PMC3901462] [PubMed: 24447897]
- 8.
Chomel B. Lyme disease. Rev Sci Tech. 2015 Aug;34(2):569-76. [PubMed: 26601457]
- 9.
Wilson W, Taubert KA, Gewitz M, Lockhart PB, Baddour LM, Levison M, Bolger A, Cabell CH, Takahashi M, Baltimore RS, Newburger JW, Strom BL, Tani LY, Gerber M, Bonow RO, Pallasch T, Shulman ST, Rowley AH, Burns JC, Ferrieri P, Gardner T, Goff D, Durack DT.
, American Heart Association Rheumatic Fever, Endocarditis, and Kawasaki Disease Committee. American Heart Association Council on Cardiovascular Disease in the Young. American Heart Association Council on Clinical Cardiology. American Heart Association Council on Cardiovascular Surgery and Anesthesia. Quality of Care and Outcomes Research Interdisciplinary Working Group. Prevention of infective endocarditis: guidelines from the American Heart Association: a guideline from the American Heart Association Rheumatic Fever, Endocarditis, and Kawasaki Disease Committee, Council on Cardiovascular Disease in the Young, and the Council on Clinical Cardiology, Council on Cardiovascular Surgery and Anesthesia, and the Quality of Care and Outcomes Research Interdisciplinary Working Group. Circulation. 2007 Oct 09;116(15):1736-54. [PubMed: 17446442]- 10.
Germack M, Sedgley CM, Sabbah W, Whitten B. Antibiotic Use in 2016 by Members of the American Association of Endodontists: Report of a National Survey.
J Endod. 2017 Oct;43(10):1615-1622. [PubMed: 28754406]- 11.
Bonifaz A, Tirado-Sánchez A, Calderón L, Montes de Oca G, Torres-Camacho P, Ponce RM. Treatment of cutaneous actinomycosis with amoxicillin/clavulanic acid. J Dermatolog Treat. 2017 Feb;28(1):59-64. [PubMed: 27151779]
- 12.
Bernatová S, Samek O, Pilát Z, Serý M, Ježek J, Jákl P, Siler M, Krzyžánek V, Zemánek P, Holá V, Dvořáčková M, Růžička F. Following the mechanisms of bacteriostatic versus bactericidal action using Raman spectroscopy. Molecules. 2013 Oct 24;18(11):13188-99. [PMC free article: PMC6270526] [PubMed: 24284484]
- 13.
Weber DJ, Tolkoff-Rubin NE, Rubin RH. Amoxicillin and potassium clavulanate: an antibiotic combination. Mechanism of action, pharmacokinetics, antimicrobial spectrum, clinical efficacy and adverse effects. Pharmacotherapy. 1984 May-Jun;4(3):122-36. [PubMed: 6739312]
- 14.
Reed MD. Optimal antibiotic dosing. The pharmacokinetic-pharmacodynamic interface.
Postgrad Med. 2000 Dec;108(7 Suppl Contemporaty):17-24. [PubMed: 19667545]- 15.
Vodovar D, Thomas L, Mongardon N, Lepeule R, Lebrun-Vignes B, Biour M, Netzer F, Haouache H, Le Beller C, Dhonneur G. Dramatic Increase of Amoxicillin-Induced Crystal Nephropathy Found in a Cohort Study of French Pharmacovigilance Centers. Antimicrob Agents Chemother. 2018 Mar;62(3) [PMC free article: PMC5826165] [PubMed: 29263078]
- 16.
Damkier P, Brønniche LMS, Korch-Frandsen JFB, Broe A. In utero exposure to antibiotics and risk of congenital malformations: a population-based study. Am J Obstet Gynecol. 2019 Dec;221(6):648.e1-648.e15. [PubMed: 31260651]
- 17.
Drugs and Lactation Database (LactMed®) [Internet]. National Institute of Child Health and Human Development; Bethesda (MD): Jan 18, 2021. Amoxicillin. [PubMed: 29999946]
- 18.
Gopal Rao G, Mahankali Rao CS, Starke I. Clostridium difficile-associated diarrhoea in patients with community-acquired lower respiratory infection being treated with levofloxacin compared with beta-lactam-based therapy.
J Antimicrob Chemother. 2003 Mar;51(3):697-701. [PubMed: 12615873]- 19.
Asim M, Ahmad F, Akhtar M. Florid Interstitial Hemorrhages: A Novel Feature of Amoxicillin-Clavulanate-Induced Acute Tubulointerstitial Nephritis. Am J Case Rep. 2021 Mar 15;22:e928989. [PMC free article: PMC7980086] [PubMed: 33716294]
- 20.
Ferrari B, Fogazzi GB, Garigali G, Messa P. Acute interstitial nephritis after amoxycillin with hematuria, red blood cell casts and hematuria-induced acute tubular injury. Clin Nephrol. 2013 Aug;80(2):156-60. [PubMed: 22607916]
- 21.
Torres MJ, Blanca M. The complex clinical picture of beta-lactam hypersensitivity: penicillins, cephalosporins, monobactams, carbapenems, and clavams. Med Clin North Am. 2010 Jul;94(4):805-20, xii. [PubMed: 20609864]
- 22.
LiverTox: Clinical and Research Information on Drug-Induced Liver Injury [Internet]. National Institute of Diabetes and Digestive and Kidney Diseases; Bethesda (MD): Oct 20, 2020.
Amoxicillin. [PubMed: 31643191]- 23.
Philbrick AM, Ernst ME. Amoxicillin-associated hemorrhagic colitis in the presence of Klebsiella oxytoca. Pharmacotherapy. 2007 Nov;27(11):1603-7. [PubMed: 17963468]
- 24.
Alarcón E, Sansosti A, Navarro B, Claver Á, Botey E, Cisteró-Bahima A, Bartra J. Amoxicillin-Induced Aseptic Meningitis: 2 Case Reports and Appraisal of the Literature. J Investig Allergol Clin Immunol. 2019 Jun;29(3):248-250. [PubMed: 31219042]
- 25.
Curtis BR. Non-chemotherapy drug-induced neutropenia: key points to manage the challenges. Hematology Am Soc Hematol Educ Program. 2017 Dec 08;2017(1):187-193. [PMC free article: PMC6142577] [PubMed: 29222255]
- 26.
Fathallah N, Ouni B, Mokni S, Baccouche K, Atig A, Ghariani N, Azzabi A, Denguezli M, Slim R, Ben Salem C. [Drug-induced vasculitis]. Therapie. 2019 Jun;74(3):347-354. [PubMed: 30173896]
- 27.
Shenoy ES, Macy E, Rowe T, Blumenthal KG.
Evaluation and Management of Penicillin Allergy: A Review. JAMA. 2019 Jan 15;321(2):188-199. [PubMed: 30644987]- 28.
Reed MD. Clinical pharmacokinetics of amoxicillin and clavulanate. Pediatr Infect Dis J. 1996 Oct;15(10):949-54. [PubMed: 8895939]
- 29.
Sutter R, Rüegg S, Tschudin-Sutter S. Seizures as adverse events of antibiotic drugs: A systematic review. Neurology. 2015 Oct 13;85(15):1332-41. [PubMed: 26400582]
- 30.
Cerba Y, Grosjean J, Forestier E, Rogeaux O, Bally S, Croze L, Maynard C, Morel B, Philit JB, Fourcade J. [Amoxicillin induced crystal nephropathy : Monitoring of residual plasma levels]. Nephrol Ther. 2021 Oct;17(6):428-433. [PubMed: 34034971]
- 31.
Maher JF. Principles of dialysis and dialysis of drugs. Am J Med. 1977 Apr;62(4):475-81. [PubMed: 851116]
- 32.
Adkinson NF, Mendelson LM, Ressler C, Keogh JC. Penicillin minor determinants: History and relevance for current diagnosis.
Ann Allergy Asthma Immunol. 2018 Nov;121(5):537-544. [PubMed: 30248407]- 33.
Spiller HA, Griffith JR. The value and evolving role of the U.S. Poison Control Center System. Public Health Rep. 2009 May-Jun;124(3):359-63. [PMC free article: PMC2663870] [PubMed: 19445410]
- 34.
Dyar OJ, Huttner B, Schouten J, Pulcini C., ESGAP (ESCMID Study Group for Antimicrobial stewardshiP). What is antimicrobial stewardship? Clin Microbiol Infect. 2017 Nov;23(11):793-798. [PubMed: 28882725]
- 35.
Nathwani D, Varghese D, Stephens J, Ansari W, Martin S, Charbonneau C. Value of hospital antimicrobial stewardship programs [ASPs]: a systematic review. Antimicrob Resist Infect Control. 2019;8:35. [PMC free article: PMC6373132] [PubMed: 30805182]
Disclosure: Bobak Akhavan declares no relevant financial relationships with ineligible companies.
Disclosure: Niloufar Khanna declares no relevant financial relationships with ineligible companies.

Disclosure: Praveen Vijhani declares no relevant financial relationships with ineligible companies.
What are antibiotics? – article on the website Aptechestvo, Nizhny Novgorod
Antibiotics are a group of drugs that are used in the treatment of bacterial infections. Bacteria are living microorganisms that, having penetrated into the human body, begin active life and reproduction. The effect of antibiotic therapy is the direct destruction of the pathogen, as well as slowing down the reproduction of pathogens. In connection with these antibacterial drugs are divided into 2 large groups: bactericidal – destroying the bacterium itself, as well as bacteriostatic, inhibiting their growth. In addition, antibiotics have a narrow and broad spectrum of action. Narrow-spectrum drugs destroy the infection selectively, while broad-spectrum drugs destroy most of the microorganisms, including those that benefit humans. What antibiotics to take for the treatment of various diseases should be decided by the doctor after the diagnosis.
Taking such drugs at your own discretion is fraught with complications.
Fluoroquinolones
They suppress the activity of enzymes involved in the formation of bacterial DNA, as a result of which the infection dies. The drugs are available in the form of tablets, injections, ophthalmic drops. Indications for appointment:
This group of drugs:
Ciprofloxacin;
Ofloxacin;
Pefloxacin;
Norfloxacin.
Aminoglycosides
Broad-spectrum agents that kill most types of Gram-negative aerobic and facultative bacteria. The active substance disrupts the process of protein synthesis, as a result of which the pathogen is destroyed and dies.
Aminoglycosides are poorly absorbed when taken orally, so, as a rule, they are prescribed as intravenous or intramuscular injections. Members of this group:
Amikacin;
Gentamicin;
Kanamycin;
Neomycin;
Plazomycin;
Streptomycin.

As a rule, these drugs are used in combination with other antibiotics to treat such infectious diseases:
Tetracyclines
Bacteriostatic antibiotics that retard the growth of pathogenic microorganisms, but do not completely destroy them. As a result, the reproduction of the infection stops, and it gradually dies.
Tetracyclines have a wide spectrum of activity, with pronounced activity against aerobic gram-positive and gram-negative bacteria. Tetracyclines are not prescribed for children under 8 years of age, since long-term use causes a number of serious complications.
The drugs of this group can be prescribed in tablet forms and in the form of injections. For the treatment of ophthalmic infections, ointments are produced, the active substance of which is tetracycline.
Medicines:
doxycycline;
minocycline;
Tetracycline;
Oxytetracycline.

Diseases for which tetracyclines are prescribed:
Macrolides
They suppress vital activity and prevent the reproduction of anaerobic and aerobic gram-positive bacteria. Preparations of this group are used in the treatment of bronchopulmonary infections, tonsillitis, otitis, scarlet fever, intestinal infections. Medicines that are included in this group:
Erythromycin;
Azithromycin;
Clarithromycin;
Spiramycin.
Penicilli
A group of antibiotics produced by the fungus Penicillium. Penicilli are active against most Gram-positive and some Gram-negative bacteria. This group of drugs:
Amoxicillin;
Augumetin;
Amoxiclav;
Flemoxin Slutab.
Cephalosporins
These are bactericidal beta-beta-lactam antibiotics that interfere with cell protein synthesis.
There are 5 generations of cephalosporins. The active substance penetrates well into most body fluids, having a pronounced bactericidal effect. Cephalosporins are used for uncomplicated skin and soft tissue infections caused by staphylococcal and streptococcal bacteria. This group of drugs:
Ceftriaxone;
Cefodox;
Cefix;
Tsepefim.
Bacteria are organisms that do not live long, but in order to restore their population, they multiply rapidly, and, accordingly, quickly mutate, adapting to new living conditions. Microorganisms that survive after taking antibiotics become resistant to them. Their offspring also become immune to a particular drug.
Antibiotic resistance is a common problem of modern man, which causes serious complications. A person who has tried many antibiotics, that is, self-medicated, is at risk for patients with antibiotic resistance.
Very often they die before a specialist can pick up a drug that works against a specific pathogen. Therefore, it is important to follow the recommendations of the doctor and take antibacterial agents strictly according to an individual scheme.
Which antibiotic should be chosen for effective treatment?
If you need an antibiotic for treatment, read our article. We will talk about the different types of antibiotics, their side effects and the correct dosage. Find an effective remedy to eliminate the disease.
Antibiotics are medicines used to treat infectious diseases. They are able to kill or stop the growth of bacteria. However, choosing the right antibiotic can be difficult because not all drugs may be effective for certain types of infections. In addition, many patients face the problem of choosing an antibiotic that will not cause side effects or allergic reactions.
There are many factors to consider when choosing an antibiotic, such as the age and general condition of the patient, type of infection, bacterial susceptibility to the drug, and possible side effects.
Some patients may develop resistance to antibiotics, so it is important to take the drug correctly and follow your doctor’s instructions to avoid consequences.
In this article, we will review the main classes of antibiotics and their use in the treatment of various infections. We will also discuss important points to consider when choosing an antibiotic and give advice on how to minimize the risk of side effects and allergic reactions.
When is an antibiotic needed?
Antibiotics are used to fight bacterial infections. Their intake is not recommended in the treatment of viral diseases such as influenza, colds, herpes and others. This is because viruses are not killed by antibiotics, and their use can adversely affect health and cause side effects.
Antibiotics may be required for the following bacterial infections:
- sore throat;
- pneumonia;
- urethritis;
- sinusitis;
- bronchitis;
Antibiotics may also be prescribed for certain urinary tract infections, skin infections, and other bacterial infections.
But do not forget that each case is individual, and the decision to take antibiotics should only be made by a doctor after appropriate examinations and diagnosis.
Related videos:
Types of antibiotics
There are many types of antibiotics, which are divided into several classes depending on the mechanism of action and the spectrum of action on bacteria.
The first class of antibiotics are penicillins, which kill bacteria that cause infections in the body. They are the main class of antibiotics used for moderate to severe infections.
The second class are cephalosporins, which are also used to treat moderate to severe infections. These antibiotics continue to work even after the penicillins have worn off.
The third class are macrolides, which are widely used to treat respiratory and skin infections.
They are usually used only in cases where penicillins and cephalosporins do not work.
Another class of antibiotics, the aminoglycosides, are sometimes used and are often used in intensive care for severe infections. However, they may be toxic to some patients and their use should be limited.
Combination antibiotics are also available, which contain two or more classes of antibiotics in the same formulation and may be effective for infections caused by more than one bacterial species.
Less than 1.5 liters
0%
1.5-2 liters
0%
More than 2 liters
0%
How to take antibiotics correctly?
Antibiotics are powerful drugs used to fight infectious diseases. Antibiotics must be taken correctly in order to maximize the effectiveness of treatment and reduce the risk of side effects.
First, be sure to follow your doctor’s recommendations for antibiotic choice and dosage. Do not interrupt the course of treatment ahead of time, even if you already feel better.
A full course of antibiotics is needed to kill all the bacteria that caused the disease.
Second, take your antibiotics exactly on schedule and at the same time. This will help maintain a constant blood level of the drug and improve its effectiveness. If you miss a dose, don’t try to catch up, just keep taking your next dose at the usual time.
Third, don’t take antibiotics unnecessarily. If you are healthy and do not have indications for taking them, do not use antibiotics. This will only exacerbate the problem as bacteria can become resistant to the drug.
Fourth, do not combine antibiotics with other medicines without your doctor’s advice. Some drugs can interact, which can lead to serious side effects.
By following these guidelines, you will be able to take your antibiotics correctly and get the most out of your treatment. Remember that self-medication is always a risky practice, and in case of unexpected symptoms, you should immediately consult a doctor.
Why is a course of treatment necessary?
After getting a prescription for antibiotics, many patients tend to start taking them right away. However, a full course of treatment is required to achieve maximum effectiveness.
A course of treatment is a period during which a patient takes prescribed medications on a scheduled basis for a specified amount of time, usually from a few days to a few weeks. Unlike short-term use of antibiotics, a course of treatment ensures that all bacteria that caused the infection are killed.
Why is the full course of treatment so important?
- Failure to follow medication recommendations may result in recurrence of symptoms or complications.
- If antibiotics are stopped prematurely, not all bacteria will be killed, which may lead to the development of drug resistance.
- Failure to comply with treatment may lead to the emergence of a new antibiotic-resistant infection that will be difficult to treat.

Meanwhile, if the drug is taken throughout the course, the appearance of resistance to it and the likelihood of complications is reduced. Therefore, it is important not to interrupt the course of treatment even if the symptoms of the disease have already passed.
What can happen if an antibiotic is chosen incorrectly?
The wrong choice of antibiotic can lead to serious consequences, which may include:
- Failure to achieve the goal of treatment: The wrong choice of antibiotic may not eliminate the microorganism causing the infection and lead to recovery.
- Increased symptoms: Some antibiotics may worsen the symptoms of the infection, causing it to progress.
- Development of allergic reactions: Choosing the wrong antibiotic may cause an allergic reaction that can be hazardous to health. Symptoms may include swelling of the lips, face, and tongue, difficulty breathing, rash, and burning.

- Development of superinfections: Incorrect prescription of an antibiotic can also lead to the development of superinfections because some antibiotics can destroy not only pathogenic bacteria, but also beneficial bacteria inside the body that protect against the growth of harmful microorganisms.
Moreover, the misuse of antibiotics can lead to an increase in bacterial resistance to these drugs, making it more difficult to treat more serious infections in the future.
Therefore, in order to effectively treat an infection, it is necessary to choose an appropriate antibiotic and follow the indicated dosages and periods of administration, and consult a doctor before using antibiotics.
How to choose an antibiotic?
The choice of antibiotic must be approached responsibly and competently. An incorrectly selected drug can not only not lead to the expected result, but also be harmful to health. To choose the right antibiotic, several important factors must be considered.
- Diagnosis. First of all, it is necessary to correctly establish the diagnosis and, on the basis of this, select the antibiotic that is most effective in a particular case. For example, when treating influenza, you need to choose drugs that can fight the virus, not bacteria.
- Microbiological analysis. If possible, a microbiological test should be performed to determine which microorganism has caused the disease and to determine antibiotic susceptibility. This will allow you to choose the most effective drug.
- Patient’s condition. It is necessary to take into account the patient’s condition, the presence of concomitant diseases and other factors that may affect the choice of drug. For example, when treating a pregnant woman, you need to consider which antibiotic will be safe for the child.
It is also worth paying special attention to the instructions for use of the antibiotic, dosage and method of application.
It is necessary to strictly follow the recommendations of the doctor and not change the dosage or the period of treatment on your own.
The choice of antibiotic is an important step in treatment and should be left to professionals. Try not to treat yourself, but trust an experienced doctor who will select the most effective and safe drug for you.
Factors affecting the choice of antibiotic
Type of bacteria: The choice of antibiotic depends on the type of bacteria causing the infection. Some antibiotics only work against specific types of bacteria, while others are more general.
Antibiotic susceptibility: Laboratory tests determine the susceptibility of bacteria to a particular antibiotic. This allows you to prescribe the most effective drug.
Side effects: Each antibiotic may cause different side effects such as diarrhea or allergic reactions. The attending physician should take into account the possible risks and side effects when choosing a drug.
Dosage: The dosage of the antibiotic depends on the patient’s weight, age and severity of the infection. Before prescribing the drug, it is necessary to conduct an appropriate assessment.
Patients with chronic disease: Patients with chronic disease or other conditions may need to choose antibiotics that do not interact with other drugs they are taking.
Duration of treatment: In many cases it is necessary to choose drugs that can be taken for a certain period of time, for example, for 7-14 days.
Pregnancy and breastfeeding: Some antibiotics may be dangerous for women who are pregnant or breastfeeding. When choosing a drug, possible risks and side effects should be taken into account.
Price: The price of an antibiotic can be an important factor when choosing a drug. Some drugs may be more expensive than others, but may be more effective.
Basic Rules for Antibiotic Selection
Antibiotics are powerful medicines for fighting infectious diseases.
However, in order to achieve maximum effectiveness of treatment, it is necessary to take into account the basic rules for choosing an antibiotic:
- Determine the sensitivity of microorganisms to antibiotics. An incorrectly selected drug can harm the body without having the desired effect. Antibiotic sensitivity can be determined using laboratory tests.
- Choose an antibiotic based on the type of infection and the patient. In the treatment of upper respiratory tract infections, for example, broad-spectrum drugs are primarily used. However, in the case of more serious diseases, more specific treatment may be required.
- Monitor the patient during treatment. While taking medications, the patient’s condition should be monitored and treatment adjusted if necessary. It is undesirable to cancel the drug on your own without consulting your doctor.
- Follow the regimen of the drug. Violation of the antibiotic regimen may reduce its effectiveness and lead to the development of microorganism resistance to the drug.

- Avoid self-medication. Improper use of antibiotics can lead to complications and reduce the effectiveness of treatment in the future.
How not to harm?
The choice of an antibiotic for the treatment of diseases is a responsible and important point, because an incorrectly selected drug can harm health. Therefore, a number of factors should be taken into account in order to minimize the risks:
- Diagnostics. Before prescribing antibiotics, it is necessary to conduct tests and studies, a detailed examination of the patient in order to determine the causative agent of the disease and sensitivity to antibiotics. This will help you choose the most effective remedy and avoid prescribing ineffective drugs.
- Compliance with dosage and regimen. Insufficient or overdose may lead to side effects and deterioration of well-being. You should strictly adhere to the doctor’s recommendations for taking antibiotics in order to achieve maximum effectiveness of treatment.

- Healthy lifestyle. Maintain a healthy lifestyle while taking antibiotics. It is not recommended to drink alcohol, smoke, you should avoid overloading the advanced modes of work and rest, listen to your body and not neglect rest and sleep.
In general, choosing the right antibiotic, along with the above factors, can help avoid side effects and achieve a speedy recovery.
Compatibility of antibiotics with other drugs
In the treatment of infections, several drugs are often prescribed, including antibiotics. It is important to consider the compatibility of antibiotics with other drugs in order to avoid negative consequences and to carry out the treatment as efficiently as possible.
Some drugs can interact with antibiotics, reducing their effectiveness or, conversely, increasing unwanted side effects. Therefore, before starting treatment, it is important to tell your doctor about all medications you take, including vitamins, dietary supplements, and herbal preparations.
Unwanted interactions include, for example, antibiotics and anticonvulsants. This is because some antibiotics can reduce the effectiveness of anticonvulsants. Also, some antibiotics interfere with the metabolism of other drugs and may cause unwanted effects.
When taking several medications together, it is important to monitor the dosage and follow the doctor’s recommendations. Sometimes it is necessary to change the dosage or replace one of the drugs with another to avoid negative interactions. Therefore, self-medication and changing the dosage of antibiotics and other drugs without consulting a doctor is not recommended.
If you have any questions about the compatibility of antibiotics with other medicines, ask your doctor or pharmacist for advice.
Main side effects of antibiotics
When using antibiotics, be aware of possible side effects that may adversely affect the health of the patient. Some of them can be very serious.
One of the most common side effects of antibiotics is an allergic reaction, which manifests itself in the form of a skin rash, dermatitis, and even anaphylactic shock.
If these symptoms occur, stop using the antibiotic and seek medical attention.
Another side effect can be dysbacteriosis, when antibiotics destroy not only harmful but also beneficial bacteria in the intestines, which leads to indigestion and diarrhea. To prevent dysbacteriosis, it is recommended to take probiotics during antibiotic treatment.
Some antibiotics can cause sensitivity to sunlight, which can lead to burns. Therefore, during treatment, it is necessary to avoid prolonged exposure to the sun and use sunscreen.
There are also possible side effects related to the function of the genitourinary system, such as candidiasis, cystitis and even high blood pressure.
If you experience any side effects, you should consult a doctor to correct treatment or change the drug.
When should I see a doctor?
Symptoms that require a mandatory visit to a doctor:
- High body temperature (more than 38 degrees).

- Severe pain in the head, abdomen, chest or other parts of the body.
- Discoloration of the skin (appearance of a rash, spots, signs of burns).
- Changes in urination (pain, burning, blood in urine).
- Sick, prolonged cough with sputum.
Situations in which you need to call an ambulance immediately:
- Stop breathing or heartbeat.
- Bleeding, unable to stop on its own.
- Rapid deterioration after injury or other exposure.
- Urinary or fecal incontinence with significant pain.
- Signs of myocardial infarction, stroke or other dangerous conditions.
If you feel sick, don’t delay going to the doctor – it could save your life.
How to properly store antibiotics?
Antibiotics are used to treat infections and diseases. They can become useless if not properly stored. The following are general guidelines for storing antibiotics.
- Store antibiotics in a dry place .
Humidity can degrade the quality of the antibiotic and make it less effective. Therefore, it is best to store antibiotics in a dry place, perhaps even in a block of dry bags. - Store antibiotics in a cool place . High temperatures can damage antibiotics and make them less effective. Store antibiotics in a cool place, such as a refrigerator, if directed to do so.
- Store antibiotics in the original container . The original packaging contains information about the action, use, expiration date and warnings. This information is very important when using an antibiotic, so keep it in its original packaging.
- Keep antibiotics out of the reach of children and animals . Any drug, even if it is safe for humans, can be dangerous for animals. Keep antibiotics out of the reach of children and animals.
Following these recommendations can help maintain the effectiveness of antibiotics and prevent potential storage problems.
New trends in the development of antibiotics
The development of new antibiotics is a necessary task in the fight against infectious diseases. Existing drugs lose their effectiveness due to misuse and the development of resistance in bacteria.
One of the new directions in the development of antibiotics is the use of peptides. These molecules have unique properties to fight infections and are also more resistant to bacterial resistance mechanisms.
Another trend is the development of completely new classes of antibiotics, despite the difficulty of finding targets to kill microorganisms. Such drugs will have novel mechanisms of action and potentially high efficacy in fighting infections.
Another important area is to improve the effectiveness of existing antibiotics. This is facilitated by various studies, including the study of the possibility of combination therapy and the use of technologies to enhance the effect of drugs at the cellular level.
New trends in the development of antibiotics offer hope for better treatment of infectious diseases and the fight against bacterial resistance. However, more research and testing of new drugs is needed for their further use.
Alternative Therapies
Today, many people are looking for alternative therapies because they can be more pleasant and less dangerous to health than antibiotics. One such method is the use of herbs and herbal preparations.
Medical research shows that many herbs and plants contain substances that can help treat infections. For example, garlic is a natural antibiotic that can kill bacteria and fungi. The effectiveness of garlic for treating infections has long been known.
In addition, there are many other herbs and herbal preparations that can be used as alternative treatments. For example, propolis, echinacea, golden root and many others.
For example, some studies show that the use of propolis can help treat respiratory infections such as bronchitis and sinusitis.
In addition, some herbal preparations can help boost the immune system, which can help prevent infections.
In any case, before using alternative treatments, you should consult a specialist, as some plants and herbs can be hazardous to health, especially when used in large doses or in combination with other medicines.
Conclusions
The study of the microbiological characteristics of the bacterial agent is the basis for the correct choice of antibiotic for treatment. The use of antibiotics for the treatment of infections is possible only after determining the type of pathogen and its sensitivity to a particular drug.
Given the pharmacokinetic properties of antibiotics, it is important to correctly determine the frequency and dosage of administration. Some antibiotics may not be effective if the patient does not take them as recommended by the doctor.
It is important to remember that the use of antibiotics can lead to the development of resistance in bacterial pathogens.
Therefore, antibiotics should be used only when they are really needed and under the supervision of a doctor.
In general, the correct choice of antibiotic for the treatment of infections is a key factor in the effectiveness of treatment. It is necessary to take into account the individual characteristics of the patient, his state of health and the sensitivity of the bacterial agent to the drug in order to achieve the best treatment result.
Q&A:
How do you know which antibiotic is right for a specific disease?
It is best to see a doctor who can diagnose and prescribe the appropriate treatment. Microbiological studies can also be performed to help determine which bacteria caused the infection and which antibiotics will be most effective on them.
What are the side effects of using antibiotics?
Side effects may vary depending on the specific antibiotic, but in general, some of them may be: allergic reactions, intestinal problems, less often – damage to the liver or kidneys.
It is also important to understand that the use of antibiotics can lead to the development of bacterial resistance to them, which can make future treatment more difficult.
How often should antibiotics be taken?
The dosage and regimen of antibiotics depends on the specific drug and disease, so you should follow your doctor’s instructions. Often antibiotics are taken 1 to 3 times a day, depending on the type of medication and dosage.
How quickly do antibiotics take effect?
The rate of onset of effect may vary depending on the type of disease and the specific antibiotic, but in general, improvement may begin within a few days of starting treatment. However, it is important to continue taking antibiotics until the end of the course, regardless of improvement, to prevent recurrence of the disease and the development of bacterial resistance to the drug.
How to choose the right antibiotic dosage?
Antibiotic dosage depends on the specific drug and disease, so you should consult your doctor who will prescribe the optimal dosage according to your condition and medical history.

0
Top oral antibiotic classes and agents prescribed—United States, 2015
3
1
For community-acquired pneumonia, IDSA recommends a combination of amoxicillin and macrolide.[3]
[7] 
It is reported to be partially dialyzable, and therefore, immediate-release tablets can be an option for dosing after hemodialysis.[15]
Occasionally, rash and disruption of the infant’s gastrointestinal flora, resulting in diarrhea or thrush, have been reported. Consequently, amoxicillin is acceptable in nursing mothers.[17]
[27]
[19][20]
Current and Future Treatment of Helicobacter pylori Infections. Adv Exp Med Biol. 2019;1149:211-225. [PMC free article: PMC6918954] [PubMed: 31016626]
2018 WSES/SIS-E consensus conference: recommendations for the management of skin and soft-tissue infections. World J Emerg Surg. 2018;13:58. [PMC free article: PMC6295010] [PubMed: 30564282]
, American Heart Association Rheumatic Fever, Endocarditis, and Kawasaki Disease Committee. American Heart Association Council on Cardiovascular Disease in the Young. American Heart Association Council on Clinical Cardiology. American Heart Association Council on Cardiovascular Surgery and Anesthesia. Quality of Care and Outcomes Research Interdisciplinary Working Group. Prevention of infective endocarditis: guidelines from the American Heart Association: a guideline from the American Heart Association Rheumatic Fever, Endocarditis, and Kawasaki Disease Committee, Council on Cardiovascular Disease in the Young, and the Council on Clinical Cardiology, Council on Cardiovascular Surgery and Anesthesia, and the Quality of Care and Outcomes Research Interdisciplinary Working Group. Circulation. 2007 Oct 09;116(15):1736-54. [PubMed: 17446442]
J Endod. 2017 Oct;43(10):1615-1622. [PubMed: 28754406]
Postgrad Med. 2000 Dec;108(7 Suppl Contemporaty):17-24. [PubMed: 19667545]
J Antimicrob Chemother. 2003 Mar;51(3):697-701. [PubMed: 12615873]
Amoxicillin. [PubMed: 31643191]
Evaluation and Management of Penicillin Allergy: A Review. JAMA. 2019 Jan 15;321(2):188-199. [PubMed: 30644987]
Ann Allergy Asthma Immunol. 2018 Nov;121(5):537-544. [PubMed: 30248407]


A full course of antibiotics is needed to kill all the bacteria that caused the disease.





Humidity can degrade the quality of the antibiotic and make it less effective. Therefore, it is best to store antibiotics in a dry place, perhaps even in a block of dry bags.